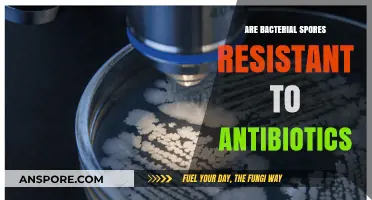
Are Bacterial Spores Resistant to Antibiotics? Unraveling the Mystery

The question of whether angiosperm eggs are spores is a fascinating one that delves into the reproductive biology of flowering plants. Angiosperms, or flowering plants, are characterized by their unique reproductive structures, including flowers and fruits. Within these structures, the female gametophyte, known as the embryo sac, contains the egg cell. While both eggs and spores are involved in plant reproduction, they serve distinct functions. Spores are typically haploid cells produced by plants for asexual reproduction or to develop into gametophytes, whereas angiosperm eggs are female gametes that, upon fertilization, develop into the embryo of a new plant. Therefore, angiosperm eggs are not spores but rather specialized cells integral to sexual reproduction in these plants.
| Characteristics | Values |
|---|---|
| Nature of Angiosperm Eggs | Angiosperm eggs are not spores; they are female gametophytes (embryo sacs) produced within the ovule of a flower. |
| Nature of Spores | Spores are haploid reproductive cells produced by plants (including ferns, mosses, and some gymnosperms) for asexual or sexual reproduction. |
| Location | Angiosperm eggs are found inside the ovule, which is part of the flower's pistil. Spores are typically produced in sporangia, often located on leaves or specialized structures. |
| Function | Angiosperm eggs are involved in sexual reproduction, requiring fertilization by pollen (male gamete). Spores can be involved in both asexual (e.g., dispersal) and sexual reproduction (e.g., in alternation of generations). |
| Ploidy | Angiosperm eggs are haploid (n), as are spores. However, angiosperm eggs are part of a larger reproductive strategy involving diploid (2n) plants. |
| Development | Angiosperm eggs develop into embryos after fertilization. Spores develop into gametophytes, which then produce gametes. |
| Dispersal | Angiosperm eggs are not dispersed; they remain within the ovule. Spores are often dispersed by wind, water, or animals. |
| Life Cycle | Angiosperms have a dominant sporophyte phase with a reduced gametophyte phase. Spores are part of the alternation of generations in plants like ferns and mosses. |
| Structure | Angiosperm eggs are part of the female gametophyte (embryo sac), which includes other cells like polar nuclei. Spores are single cells with a protective wall. |
| Taxonomic Group | Angiosperms are flowering plants (e.g., roses, oaks). Spores are produced by non-flowering plants (e.g., ferns, mosses) and some gymnosperms. |
Explore related products
$13.99 $17.99
What You'll Learn
- Egg vs. Spore Definition: Clarify differences between angiosperm eggs and spores in reproductive biology
- Angiosperm Life Cycle: Explore how eggs function in the angiosperm life cycle stages
- Spores in Plants: Examine if angiosperms produce spores and their role
- Egg Development: Trace the development of angiosperm eggs within ovules
- Reproductive Structures: Compare angiosperm reproductive structures to spore-producing plants

Egg vs. Spore Definition: Clarify differences between angiosperm eggs and spores in reproductive biology
Angiosperms, or flowering plants, produce eggs as part of their reproductive cycle, but these eggs are fundamentally different from spores. While both are reproductive structures, their roles, development, and functions diverge significantly. Angiosperm eggs are female gametocytes that, upon fertilization, develop into embryos within seeds. Spores, in contrast, are haploid cells produced by plants like ferns and fungi, capable of growing into new individuals without fertilization. This distinction highlights a critical evolutionary difference in reproductive strategies.
To clarify, angiosperm eggs are housed within the ovule, protected by the ovary of the flower. After pollination, the egg is fertilized by a sperm from pollen, leading to the formation of a diploid zygote. This zygote develops into the embryonic plant, which, along with stored nutrients, becomes the seed. Spores, however, are typically produced through asexual means, such as meiosis in sporangia. For example, fern spores germinate into gametophytes, which then produce eggs and sperm. This two-stage life cycle (alternation of generations) contrasts sharply with the direct seed development in angiosperms.
A key practical difference lies in their environmental roles. Angiosperm seeds are adapted for dispersal and dormancy, ensuring survival in diverse conditions. Spores, being lightweight and numerous, are optimized for wind dispersal but are more vulnerable to environmental stresses. For instance, a single dandelion plant can produce thousands of seeds, while a fern releases millions of spores to increase the odds of successful colonization. Understanding these adaptations is crucial for horticulture, conservation, and agriculture.
From a biological perspective, the distinction between eggs and spores reflects broader evolutionary trends. Angiosperms’ reliance on seeds has contributed to their dominance in terrestrial ecosystems, offering protection and nutrient storage for developing embryos. Spores, while less protected, allow for rapid colonization of new habitats, a strategy favored by early land plants and fungi. This comparison underscores the diversity of reproductive mechanisms in the plant kingdom and their ecological implications.
In summary, while both angiosperm eggs and spores serve reproductive purposes, their structures, functions, and life cycles differ markedly. Eggs are integral to sexual reproduction and seed formation in flowering plants, whereas spores are asexual units for dispersal and growth in non-seed plants. Recognizing these differences not only clarifies reproductive biology but also informs practical applications in botany, ecology, and agriculture.
Are Fern Spores Harmful to Humans? Uncovering the Truth
You may want to see also

Angiosperm Life Cycle: Explore how eggs function in the angiosperm life cycle stages
Angiosperms, commonly known as flowering plants, rely on a complex life cycle that hinges on the interplay between eggs and spores. Unlike ferns or mosses, where spores are the primary reproductive units, angiosperms produce seeds that encapsulate the embryonic plant. Central to this process is the egg cell, housed within the ovule of the flower. The egg’s role is not to disperse like a spore but to fuse with a sperm cell during fertilization, initiating the development of a new plant. This distinction highlights why angiosperm eggs are not spores—they serve as the foundation for seed formation rather than as independent, dispersible units.
To understand the egg’s function, consider the angiosperm life cycle stages. It begins with sporophyte dominance, where the mature plant produces flowers. Within the flower’s ovary, the ovule contains the egg cell. Pollination introduces pollen (male gametophyte) to the stigma, triggering the growth of a pollen tube that delivers sperm to the ovule. Fertilization occurs when one sperm fuses with the egg, forming the zygote, and the other fuses with the central cell, initiating endosperm development. This double fertilization is unique to angiosperms and underscores the egg’s critical role in both embryonic and nutrient formation.
Practical observation of this process can be done by dissecting a flower post-pollination. Examine the ovary under a microscope to locate the ovule and observe the pollen tube’s progression. For educators or enthusiasts, this activity provides tangible insight into the egg’s function. Note that the egg’s success depends on environmental factors like temperature and humidity, which influence pollen viability and tube growth. For optimal results, maintain temperatures between 20–25°C and ensure adequate moisture during pollination experiments.
Comparatively, spores in non-vascular plants like ferns are haploid cells designed for dispersal and survival in harsh conditions. In contrast, angiosperm eggs are protected within the ovule and seed, ensuring direct development into a new plant. This evolutionary adaptation allows angiosperms to dominate diverse ecosystems, from rainforests to deserts. The egg’s role in seed formation is a key factor in their success, as seeds provide nutrients and protection during germination, unlike spore-dependent plants.
In conclusion, the angiosperm egg is not a spore but a specialized cell integral to the plant’s reproductive strategy. Its function in fertilization and seed development distinguishes angiosperms from spore-reproducing plants. By examining the life cycle stages and observing key processes like double fertilization, one gains a deeper appreciation for the egg’s role in sustaining angiosperm diversity and dominance. Practical experiments and comparative analysis further illuminate this unique aspect of plant biology.
Can Air Purifiers Effectively Remove Mold Spores from Indoor Air?
You may want to see also

Spores in Plants: Examine if angiosperms produce spores and their role
Angiosperms, commonly known as flowering plants, dominate terrestrial ecosystems and are celebrated for their vibrant blooms and seed-bearing fruits. Yet, a closer examination of their life cycle reveals a surprising absence: angiosperms do not produce spores as part of their reproductive strategy. Unlike ferns, mosses, and fungi, which rely on spores for dispersal and survival, angiosperms have evolved a more complex reproductive system centered around seeds. This distinction is fundamental to understanding their evolutionary success and ecological role.
To appreciate why angiosperms eschew spores, consider their life cycle. Angiosperms reproduce sexually through flowers, where pollen (male gametophyte) fertilizes the ovule (female gametophyte), resulting in seeds. These seeds, encased in protective coats, contain embryonic plants and nutrient reserves, ensuring survival in diverse environments. Spores, in contrast, are haploid cells produced by non-flowering plants and fungi for asexual reproduction or dispersal. While efficient for colonizing new habitats, spores lack the protective and nutritional advantages of seeds, making them less suited to angiosperm needs.
The absence of spores in angiosperms is not a limitation but a testament to their evolutionary ingenuity. Seeds provide angiosperms with a competitive edge, enabling them to thrive in varied climates and soil conditions. For instance, the hard coat of a sunflower seed protects the embryo from desiccation, while the endosperm supplies nutrients for germination. This seed-based strategy allows angiosperms to dominate forests, grasslands, and agricultural systems, outcompeting spore-producing plants in most ecosystems.
However, this doesn’t mean spores are irrelevant to angiosperms. While angiosperms don’t produce spores, they coexist with spore-producing organisms in complex ecosystems. For example, fungi, which reproduce via spores, form symbiotic relationships with angiosperm roots (mycorrhizae), enhancing nutrient uptake. Understanding this interplay highlights the interconnectedness of plant reproductive strategies and their collective role in ecosystem stability.
In practical terms, gardeners and botanists can leverage this knowledge to optimize plant care. For angiosperms, focus on seed health and soil conditions to ensure successful germination. For spore-producing plants like ferns, maintain high humidity and provide shade to mimic their natural habitat. By recognizing the unique reproductive mechanisms of each group, enthusiasts can foster thriving gardens and contribute to biodiversity conservation. Ultimately, while angiosperms do not produce spores, their seed-centric approach underscores their adaptability and ecological dominance.
Is Milky Spore Safe for Dogs? A Pet Owner's Guide
You may want to see also
Explore related products

Egg Development: Trace the development of angiosperm eggs within ovules
Angiosperm eggs, unlike spores, are not dispersal units but rather the female gametophytes that develop within the protective confines of the ovule. This distinction is crucial for understanding their development, which is a highly coordinated process involving multiple stages. The journey begins with the formation of the megaspore mother cell within the nucellus of the ovule. Through meiosis, this cell gives rise to four haploid megaspores, only one of which survives to become the functional megaspore. This survivor undergoes three rounds of mitosis, resulting in an eight-nucleate embryo sac—the female gametophyte. Within this structure, one nucleus develops into the egg cell, positioned near the micropyle, ready for fertilization.
To trace this development effectively, consider the ovule as a microcosm of precision and timing. The megaspore mother cell’s division is not random but regulated by hormonal cues, primarily auxin and cytokinin, which ensure the ovule’s readiness for pollination. For instance, in *Arabidopsis thaliana*, the transition from megaspore to embryo sac takes approximately 4–5 days post-meiosis, with environmental factors like temperature influencing the pace. Practical observation of this process often involves fixing ovules in FAA solution (formaldehyde, acetic acid, and ethanol) and staining with DAPI to visualize nuclei under fluorescence microscopy.
A comparative analysis highlights the contrast between angiosperm eggs and spores. While spores are resilient, desiccation-tolerant structures designed for dispersal, angiosperm eggs are delicate, short-lived, and dependent on the ovule’s protective environment. This vulnerability underscores the importance of the ovule’s integuments, which shield the developing egg from mechanical damage and pathogens. For example, in maize (*Zea mays*), the integuments secrete antimicrobial compounds that safeguard the embryo sac during its critical development phase.
Instructively, understanding egg development within ovules has practical applications in agriculture and biotechnology. Techniques like in vitro embryo sac culture, though challenging, offer insights into gametophyte development and can aid in breeding programs. For instance, researchers have successfully cultured embryo sacs of *Oryza sativa* (rice) by optimizing nutrient media with 2% sucrose, 1 mg/L thiamine, and 0.5 mg/L naphthaleneacetic acid. Such advancements pave the way for genetic manipulation and crop improvement.
Persuasively, the study of angiosperm egg development is not merely academic but essential for addressing global food security challenges. By unraveling the mechanisms governing egg formation, scientists can enhance seed viability, improve crop yields, and develop resilient varieties. For example, understanding the role of auxin in megasporogenesis could lead to targeted interventions that mitigate ovule abortion, a common issue in stressed plants. This knowledge bridges the gap between fundamental biology and applied agriculture, making it a critical area of focus for both researchers and farmers.
Are All Purple Spore Prints Reliable? Unveiling the Truth
You may want to see also

Reproductive Structures: Compare angiosperm reproductive structures to spore-producing plants
Angiosperms, or flowering plants, and spore-producing plants like ferns and mosses represent two distinct reproductive strategies in the plant kingdom. The key difference lies in their reproductive structures and the methods by which they propagate. Angiosperms produce seeds enclosed within fruits, while spore-producing plants rely on spores for reproduction. This fundamental distinction shapes their life cycles, ecological roles, and evolutionary success.
Consider the reproductive structures of angiosperms. Flowers are the reproductive organs, containing male (stamens) and female (pistils) parts. Pollination, often facilitated by animals or wind, transfers pollen from the stamen to the stigma, leading to fertilization. The ovary then develops into a fruit, which protects and disperses the seeds. Each seed contains an embryo, stored food, and a protective coat, ensuring the next generation’s survival. In contrast, spore-producing plants lack flowers and seeds. Instead, they generate spores in structures like sporangia. These spores are haploid, single-celled, and lightweight, allowing for wind dispersal. Upon landing in a suitable environment, a spore germinates into a gametophyte, which produces gametes for sexual reproduction. This process is simpler but less protected than angiosperm seed development.
Analyzing these systems reveals trade-offs. Angiosperms invest more energy in producing seeds, but this strategy offers greater protection and nutrient provision for offspring. Spore-producing plants, on the other hand, rely on quantity and dispersal efficiency. Their spores can survive harsh conditions, but success depends on finding the right environment. For example, ferns release thousands of spores to ensure a few land in fertile soil. Angiosperms, however, produce fewer seeds but increase their chances of survival through fruits and dispersal mechanisms like wind, water, or animals.
Practical observations highlight these differences. In gardening, angiosperms require pollination and seed sowing, while ferns thrive through spore scattering. For educators, demonstrating these reproductive structures—dissecting a flower versus examining fern undersides—provides a tangible comparison. Understanding these systems also aids conservation efforts, as spore-producing plants often dominate early succession stages, while angiosperms stabilize mature ecosystems.
In conclusion, the reproductive structures of angiosperms and spore-producing plants reflect their evolutionary adaptations. Angiosperms’ seeds and fruits ensure offspring survival, while spores offer resilience and dispersal. Both strategies are effective, tailored to their environments, and essential for biodiversity. By studying these differences, we gain insights into plant evolution and practical applications in horticulture and ecology.
Mastering Mushroom Cultivation: Growing Spores from Syringe Step-by-Step
You may want to see also
Frequently asked questions
No, angiosperm eggs are not spores. Eggs in angiosperms are female gametes involved in sexual reproduction, while spores are asexual reproductive units found in plants like ferns and mosses.
Angiosperms do not produce spores for reproduction. They rely on seeds, which develop from fertilized eggs, for their life cycle, unlike spore-producing plants like ferns and fungi.
Angiosperm eggs are part of sexual reproduction, requiring fertilization by pollen to form a seed. Spores, in contrast, are asexual and can develop into new plants without fertilization, as seen in non-seed plants.